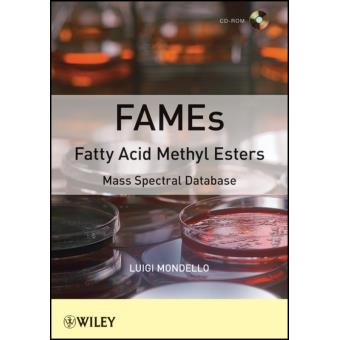
Fames Fatty Acid Methyl Esters Mass Spectral Database - 1

Fames Fatty Acid Methyl Esters Mass Spectral Database
Luigi Mondello
Resumo
Fames Fatty Acid Methyl Esters Mass Spectral Database
60b6260i62Fatty acids60/i6260/b62 are important compounds in food analysis, since they are sample8211specific. They can be used as markers or their profile can be used as a fingerprint 60i62e. g60/i62. , bacteria fatty acids or to reveal fraud 60i62e. g60/i62. , seed oil added to olive oil.
60b6260i62Fatty acids60/i6260/b62 are important compounds in food analysis, since they are sample8211specific. They can be used as markers or their profile can be used as a fingerprint 60i62e. g60/i62. , bacteria fatty acids or to reveal fraud 60i62e. g60/i62. , seed oil added to olive oil.

Fames Fatty Acid Methyl Esters Mass Spectral Database
Resumo
Fames Fatty Acid Methyl Esters Mass Spectral Database
60b6260i62Fatty acids60/i6260/b62 are important compounds in food analysis, since they are sample8211specific. They can be used as markers or their profile can be used as a fingerprint 60i62e. g60/i62. , bacteria fatty acids or to reveal fraud 60i62e. g60/i62. , seed oil added to olive oil.
60b6260i62Fatty acids60/i6260/b62 are important compounds in food analysis, since they are sample8211specific. They can be used as markers or their profile can be used as a fingerprint 60i62e. g60/i62. , bacteria fatty acids or to reveal fraud 60i62e. g60/i62. , seed oil added to olive oil.
Publicidade
Avaliações dos nossos clientes
Fames Fatty Acid Methyl Esters Mass Spectral Database
Sê o primeiro a dar
a tua opinião sobre este produto
Características
- Editora
-
Wiley-blackwell
- Idiomas
-
Inglês
- Data de lançamento
-
20/12/2011
- Colecção
-
Other technologies & applied sciences
- Peso
-
88
- EAN
-
9781118143940
Publicidade
Publicidade